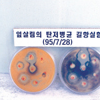

흙살림이 걸어온 길

2020 ~ 현재
2025

흙살림꾸러미 5000플러스 프로젝트
신간 <흙아 미안해> 출판 기념회
흙의 날 기념 ‘흙의 노래’ 특별전시회
의성 산불 피해 농가 균배양체 후원
‘벽우네 토마토 상회’ 새단장
흙살림 나눔실천 감사패 수상
서울시 친환경 급식 공급업체 선정
희망얼굴 칭찬 릴레이 업무협약
청주지역 친환경 마늘,양파 활성화 헙무협약
우리 아이 먹거리 지원사업 협약
2024

오창흙살림아트센터 개관
생분해 플라스틱 퇴비화 시험
흙과 몸을 살리는 자연치유운동 협약
‘텃밭의 과학’ 무료 열린 강좌
‘상자논 모내기’ 체험 행사
2024 탄소중립 흙 살리기 박람회 참가
KOICA 초청 쿠바 연수단 방문
흙살림 청주센터 저장고 신축 상량식
2023

태국에 농자재‘바이오슘’ 첫 수출
베트남 푸엔성 PY바이오사와 협약식
‘흙의 날’ 기념 흙살림 주말 장터 개장
흙살림바이오 비전 선포식
임산부 친환경 농산물 공급업체 선정
괴산군민장학회에 장학금 기탁
흙살림마켓투유오창매장 개장
청주 북이면 지역돌봄기능강화 협약
친환경 스마트팜 배지 용토 연구
2022

매헌 윤봉길 월진회와 업무협약
충북도와 친환경농산물 유통활성화 업무협약
흙살림 괴산 농자재센터 개소
충해방제 ‘충식이’ 필리핀 12차 수출
괴산세계유기농엑스포 참가 및 후원금 1,500만원 기탁
‘희망얼굴’ 흙살림 장터 개장
키르기즈공화국과 유기농업 확산 협력 양해각서
경기도농업기술원과 친환경 방제 기술이전 계약
흙살림 토마토 생산자 간담회
풀무원과 함께 괴산청년농부에 낫토 퇴비 지원
청주 서문시장과 상호발전 협약식
키르기즈공화국과 유기농 협력 MOU 체결
2021

흙살림 30주년 기념 및 <흙 없인 못 살아> 책 출간
흙살림 농자재 필리핀 10차 수출
청주친환경학교급식 공급자 선정 및 성공기원제
중소벤처기업부 장관상 수상
이태근 회장 서울대 ‘상록인 대상’ 수상
직업계고 산학협력 우수기업 선정
충청북도 교육청에 장학금 전달
‘우리동네 공유냉장고’ 운영 지원 협약
흙살림 유기농 도서관 확장 이전
토종농장 치유농장으로 조성
쿠팡•오아시스 공급 개시
2020

임산부 친환경농산물 지원 시범사업 공급업체 지정
흙살림 농자재 상주판매점 개점
흙살림 황다방 필리핀 8차 수출
제주친환경농업인연합회와 상생협약서 체결
휴먼케어와 사회적농업 협약식
흙살림 친환경유통센터 준공
2010 ~ 2019
2019

흙살림 균배양체 필리핀에 100톤 수출 달성
온라인 쇼핑몰 '마켓투유' 앱 출시
베트남에 현지 해외 법인, 미생물연구소 설립
흙살림 미생물제 '흙살림 골드'‘황수화제’ 필리핀에 첫 수출
(사)호아빈의 리본과 베트남 초등생 장학금 지원 업무협약
충청북도 우수농특산물 품질인증
충북농업기술원과 친환경농업 발전 협약식
고성군 산불피해 농민 돕기 균배양체 지원
'흙을 이야기하다' 흙의 인문학 강좌 개최
충북생명산업고와 창업인력양성 상호협력협의회 개최
'산모꾸러미' 출시
농공상융합형중소기업 선정
2018

흙살림균배양체 필리핀에 100톤 수출 달성
농축수산물 전문 쇼핑몰 ‘마켓투유’ 개장
서울친환경학교급식 생산자단체 3연속 선정
베트남에 현지 해외 법인 설립
꾸러미 400회차 발송
흙나라 발효펠렛, 흙살림 아미노볼 개발
살림두부 판매액 일부 베트남 호아빈 장학금 지원
2017

(주)청풍명월클러스터와 상호업무협약
흙살림균 배양체, 필리핀에 2,3차 수출
청풍명월 본점에 핀환경 매장 개장
흙의 날 기념 친환경농업 시농제 개최
몽골/베트남 달랏에 시범농장 운영
‘충식이’, ‘유기엔16’ 등 새 농자재 출시
제1회 흙살림 농사예술제 개최
몽골 유기농업 지원 프로그램 실시
2016

특등급 유기질비료 흙살림균양체
필리핀 첫 수출
Non-GMO 친환경 왕우렁이 사료 개발
유기농업 실전농부학교 운영
흙살림 자가 인증제도 도입
흙살림상 제3회 수상자 김봉기씨
중국 푸신시와 유기농업발전 업무 조인식
독일·오스트리아 친환경농업 연수
이태근 회장, 석탑산업훈장 수훈
2015

괴산세계유기농산업엑스포 이해 워크숍 주관
모바일 쇼핑몰 개장
흙살리기 대토론회 주최
제2회 “흙살림상” 이일옹씨 수상
모잠비크 소농지원 젖염소 구매 모금운동
2014

흙살림 안전성 검사기관 지정
괴산군유기농업리더양성교육 개강
‘흙살림 꾸러미’ 우체국 쇼핑몰 입점
충해 관리용 자재 ‘흙살림 잘잡아’ 개발
‘흙살림 꾸러미’ 200회
GS슈퍼에 친환경농산물 공급
흙살림 푸드 청주센터로 확장 이전
제1회 ‘흙살림상’ 성기남 회장 수상
잔류농약 분석 320항목 확대
아시아유기농농업대회 참가자 현장 투어
2013

‘토종순례단’ 운영
흙살림연구소 장기귀농학교 개강
서울 시청 광정에서 토종 미니 박람회 개최
서울시 친환경 학교급식 공급사업자 선정
흙살림연구소 현장실습교육장(WPL) 선정
유기농업자재 시험연구기관 지정
토종연구회 추계학술대회
농산물직거래 콘테스트 꾸러미 부문 우수 사업자 선정
2012

노들섬에 토종벼 80여종 분양
이태근 회장 제 22회 일가상 농업부문 수상
사단법인 흙살림연구소로 명칭 변경
서울 광화문 논농사 프로젝트
‘현장농민연구원’ 추진
‘어린텃밭’ 등 도시농업자재 개발
쿠바식 농장 설치 운영
흙살림 꾸러미 100회 발송
2011

흙살림 창립 20주년
쌈지농부와 함께 유기농 가게 ‘농부로부터’ 개장
토종연구소 개소
텃밭상자 보급 운동
작은텃밭 그로우백 제작
이태근 회장 윤봉길 농민상 수상
세계유기농대회 토종종자 사전학술대회
2010

(사)흙살림, (사)자원순환연대 공모사업 협약식
흙살림 생활꾸러미 공급
상자텃밭 분양행사(서울 등 전국 대도시 10여곳)
토종벼 손모내기 행사 진행
괴산군 토종수집단 발대식 개최
토종벼베기 체험행사
2000 - 2009
2009

흙살림친환경영농사업단 발족
제3회 농협문화복지대상 수상(농업발전부문)
유기농가공식품 컨설팅 기관지정(농산물유통공사)
(사)두꺼비친구들, (사)흙살림 업무협약
흙살림 귀농귀촌 교육과정 운영
(사)흙살림, 일본유기농업 연구회 업무협약")
2008

흙살림 고흥군지부 창립
비료시험기관연구기관 지정(농촌진흥청)
농업경영컨설팅인증기관 지정(농식품부)
사회적기업인증(노동부)
(사)농어촌사회연구소 업무협약
(사)한국베이비시터협회 업무협약
흙살림생협준비위원회 발족
2007

흙살림친환경농업센터 1호점(괴산) 오픈
북한에 흙살림 미생물 배양원료 공급
16주년 기념행사(흙상자 나눠주기)
제5회 손모내기 체험행사
흙살림 토종 전시포장 만듬
장안농장과 업무협약
흙살림 서안성지부 창립
고흥군농업기술센터와 업무제휴 협약체결
제5회 손모내기 체험행사
흙살림 쌀 현미 품종검정 기관지정
농업인의 날 대통령표창(이태근 회장)
흙살림 한국농촌대상 연구개발부문 수상
2006

김성중회원 친환경 농업대상 우수상
태국 쌀산업 방문
흙살림 GC분석기 추가도입
흙살림 괴산군지부 창립
유기농업총서 ⑪유기재배 이것만은 알아야 한다 발행
유기농업총서 ⑫농사짓는 즐거움 발행
15주년 기념행사
흙살림 주말장터 개장
흙살림 15주년 기념행사 이철수 화백 판화전
제4회 손모내기 체험행사
북녘 미생물 고체 배양시설 지원
괴산 교육장에 햇빛발전소 설치
손두부만들기 체험행사
제4회 벼베기 체험행사 개최
일본 친환경 유기농업 연수
생명평화 환경농업 대출제 기획단 참가
흙살림 친환경 김치축제
2005

충북바이오농업대상 이태근회장 ‘우수상’
한국화학연구원과 식물내생세균균주 기술 계약 체결
무안청계면지회, 나주시지부 설립
친환경 농업분야 컨설팅 공급업체로 지정
북한에 못자리용 비닐 전달
유럽 농업연수(독일,스위스, 오스트리아)
제3회 손모내기 체험행사
유기농업총서 ⑧유기농업이 희망이다 발행
북한 흙살림 미생물 배양기설치 가동
유기농업총서 ⑨유기농업의 이론과 실제
유기농업총서 ⑩유기농업 자재의 이론과 실제 발행
인증위원회 홈페이지 오픈
FOAM(국제유기농업운동연맹) 세계대회와 학술발표회 참석(호주)
제3회 흙살림 벼베기 행사
흙살림 CI 선포식", "금강산 임직원 연수회
2004

흙살림연구소 오창센터 개장식
유기농업총서 ⑤흙을 살리는 기쁨, 땅위에서 사는 기쁨 발행
환경농업단체연합회 회장 취임(이태근 회장)
유기농업총서 ⑥참농부 발행 흙을 사랑하는 사람들의 모임(흙사모) 창립
제2회 손모내기 체험해상 개최, 창립 13주년 기념식과 쿠바식 유기농업 실험농장 개장식
제2회 벼베기, 메뚜기 잡기 체험행사 개최
(사)전국귀농운동본부와 함께 도시농업위원회 창립
2004 흙살림 인증농가대회
2003

유기농업총서 ①흙살리는 길 발행
유기농업총서 ②남은음식물 재활용 지침서 발행
유기농업총서 ③친환경농업 병충해방제 사례집 발행
제1회 손모내기 체험행사
제1회 벼베기 메뚜기잡기 체험행사
대한민국 농업과학기술살 수상
유기농업총서 ④이땅에서 농업을 하는 의미 발행
2002

친환경농산물 민간인증기관 1호 지정
환경농업단체연합회 부회장취임(이태근회장) 흙살림 친환경농산물 민간인증 제1호 농가탄생
유기농산물 인증 제1호 충남당진 정광영씨
무농약농산물 인증 제1호 부여 신암 딸기 작목반(대표 강수옥)
홍성 오리쌀 작목반 383농가 80만평 전환기 유기농산물 인증
2001

미생물농약 품목등록 시험연구기관 지정(농촌진흥청)
인턴연구원 2명 입사(한국과학재단)
새서울 친환경농장 방제사업참여
부설연구소 병역특례업체 지정 ‘가정 음식물의 환경친화적 퇴비화’ 적용
시범사업시행(쓰시협) 환경친화적 병충해 방제사례집 제작
친환경농업 선진지 견학(캐나다)
2000

흙살림 정기총회 개최(사단법인 이사 15인 신규취임)
생명공학연구소 바이오벤처센터내 흙살림기술연구소 입주
‘환경농업의 이론과 실제(개정판)’ 책자발간
흙살림 회원 2,500명 돌파
2000 흙살림 대회 및 환경 농업교육장 준공식
농업의 날 대통령 표창 수상 및 벤처기업(신기술) 지정(중소기업청)
흙살림 유산균제제 충북발명왕 특별상 수상
1991 - 1999
1999

농산물쇼핑관광(그린투어숍) 지정
학교급식에서 배출되는 음식물찌꺼기의 환경 교육적 활용방안 연구보고서 출간
도시와 농촌이 협력하는 흙살림 순환농법 자료집 출간
우리농산물 전시회(COEX)출품
사단법인 흙살림 홈페이지 개설
1998

토양미생물확대배양기 연구 보고서 출간 및 발효사료 제조기술 개발 연구
흙살림 출판사 등록
충북환경인상 수상
1997

액상종균을 이용한 법섯 생력화 재배 연구 보고서 출간
‘97흙살림대회’ 개최, 환경부장관상 수상
‘토양미생물 확대배양기 개발’ 연구
우리나라 느타리버섯 재배의 실태 및 문제점 연구 보고서 출간
1996

충북 유기농업 명예연구소 지정
천주교 환경대상 단체부문 수상
기독교 사회발전협회 지원 ‘음식물찌꺼기 발효사료 실용화 연구’ 보고서 출간
농림부 사단법인 설립 인가
음식물찌꺼기 퇴비를 이용한 국화재배 전시회
음식물찌꺼기 소멸화 연구 수행
1995
담배인삼공사 공익사업단 지원 ‘음식물쓰레기 퇴비화 실용모델 개발연구’
흙살림연구소 신축이전 및 연구기자재 보강
1994

흙살림생활농장 운영(음성) 시작
1993

흙살림연구모임 창립
1991

괴산미생물연구회 창립
(재)충북농촌개발회, 괴산소비자 협동조합, 농민들이 참여하여 창립함





